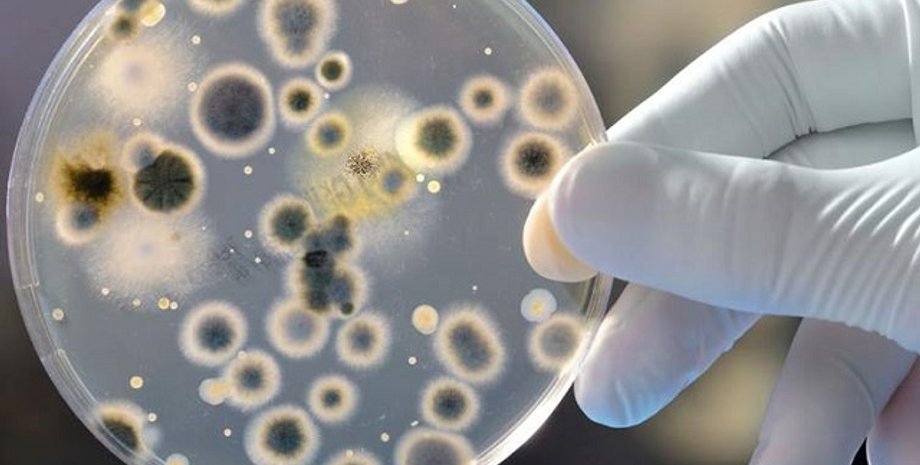
Фото из открытых источников

Китайские ученые обнаружили плесень, уничтожающую пластмассу
Aspergillus tubingensis за два месяца почти полностью разлагает пластмассу
Ученые Академии наук Китая обнаружили новый вид плесени под названием Aspergillus tubingensis, способный разлагать полиуретановые пластмассы. Статья об открытии опубликована в международном журнале "Загрязнение окружающей среды", передает Укринформ.
Один из авторов статьи, исследователь Куньминского института ботаники при Академии наук Китая Сюй Цзяньчу сказал, что новый вид плесневых грибов был обнаружен учеными в городском мусоре.
"Согласно результатам лабораторного исследования, данный вид плесневых грибов может расти на поверхности полиуретана и выделять фермент, способный катализировать биологические реакции с пластмассами, в результате которых происходит разрушение химической связи между молекулами.
По словам биолога, данный вид плесени также способен разрушать пластмассовые полимеры.
Исследователь подчеркнул, что результаты биодеградации пластмассы плесенью Aspergillus tubingensis хорошо видны уже спустя две недели, после начала процесса. Через два месяца пластмасса почти полностью разлагается.
Чтобы использовать новый вид плесени для уничтожения пластика в крупных масштабах, ученые намерены досконально изучить Aspergillus tubingensis и определить идеальные условия для быстрого и масштабного размножения.
"Использование Aspergillus tubingensis в промышленных масштабах сыграет важную роль в борьбе с загрязнением", - сказал Сюй Цзяньчу.
